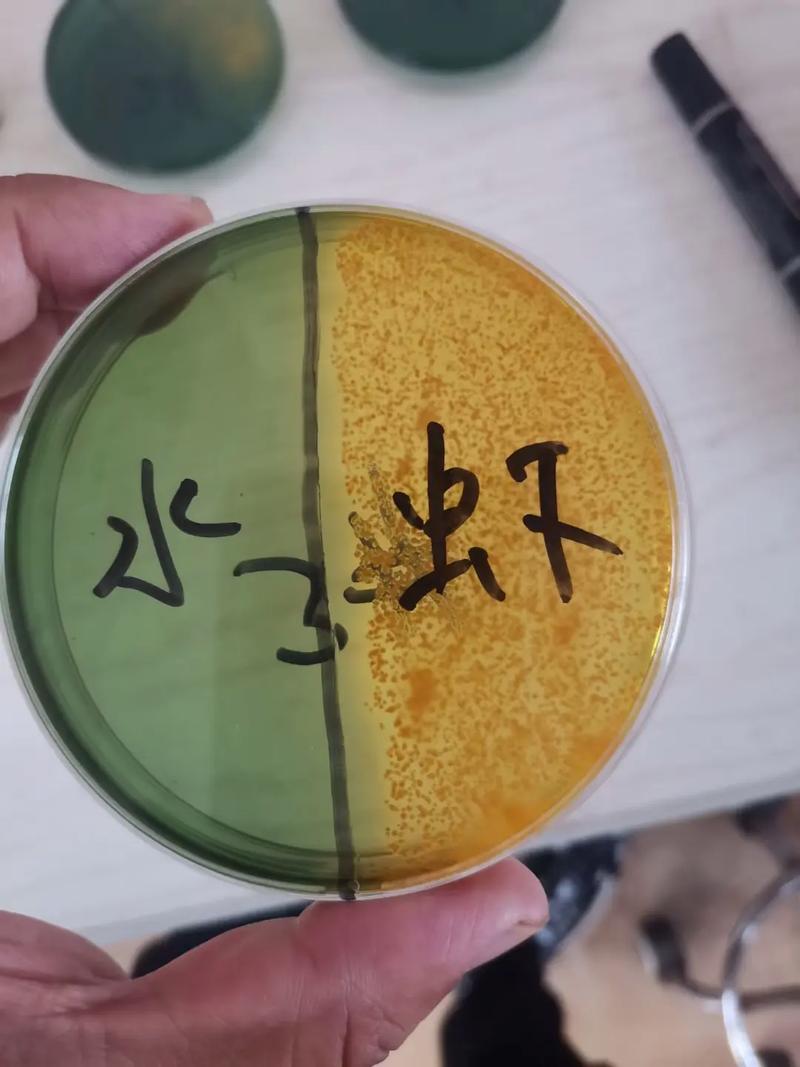
水产养殖弧菌测试标准有何新变化？-第1张图片-宁夏农业信息网
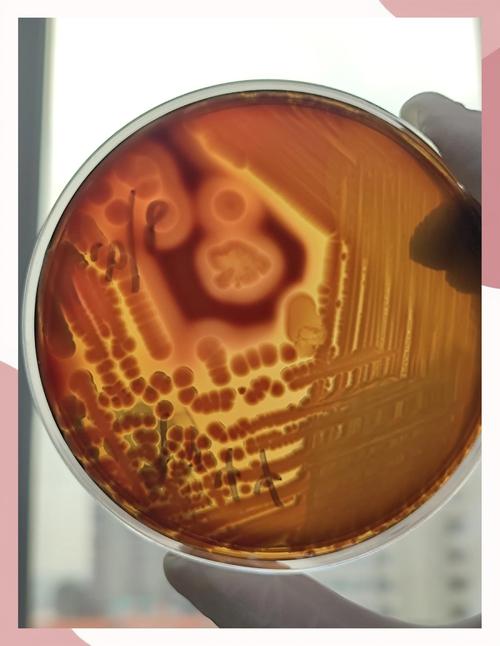
水产养殖弧菌测试标准有何新变化？-第2张图片-宁夏农业信息网

水产养殖弧菌测试标准终极指南:从检测到防控,一篇读懂!
** 本文是水产养殖从业者必备的弧菌防控指南,我们深入解读了当前主流的水产养殖弧菌测试标准,包括国标、行标及快速检测方法,并提供了从采样到报告的完整操作流程,旨在帮助您科学防控弧菌病害,降低养殖风险,保障水产健康。
引言:弧菌——水产养殖的“隐形杀手”
在水产养殖的广阔蓝海中,弧菌(Vibrio)无疑是每一位养殖户和从业者都必须警惕的“隐形杀手”,从对虾的白便综合征、烂鳃病,到鱼类的溃疡、败血症,弧菌引发的病害不仅传播迅速、死亡率高,更给整个产业链带来了巨大的经济损失。
传统的“经验养殖”模式在面对弧菌时往往力不从心,如何才能从被动治疗转向主动预防?答案就藏在科学的检测与标准化的管理中。“水产养殖弧菌测试标准”,正是我们手中那把精准防控弧菌的“金钥匙”,本文将为您系统梳理,助您彻底掌握这项核心技术。
为什么要遵循“标准”?——标准化的意义
在深入探讨具体标准之前,我们必须理解:为什么弧菌测试需要标准化?
- 结果可比性与权威性: 标准化的方法确保了不同实验室、不同时间、不同人员检测出的结果具有可比性,您拿到的报告不再是模糊的“有点多”,而是具体、可量化的数据,为后续决策提供科学依据。
- 精准预警与早期干预: 标准化的检测流程能更早、更准确地发现弧菌超标的风险,当环境水体或养殖动物体内的弧菌数量达到临界值时,我们就能立即启动防控预案,将病害扼杀在摇篮中。
- 保障产品质量与食品安全: 严格控制养殖环节的弧菌水平,直接关系到最终水产品的质量安全,这不仅是企业信誉的体现,更是对消费者健康的负责。
- 满足行业监管与出口要求: 对于出口型企业,遵守国际通行的检测标准(如ISO、FDA等)是产品进入国际市场的“通行证”,国内的大型水产企业和品牌商也越来越重视供应链的标准化检测。
核心解读:主流的水产养殖弧菌测试标准
国内水产养殖领域关于弧菌的检测标准主要分为三大类:国家标准、行业标准和快速筛查方法,了解它们,是您制定检测方案的第一步。
1 国家标准(GB):最高权威,法律依据
国家标准是检测领域的“根本大法”,具有最高的法律效力和权威性。
- 核心标准: GB 4789.7-2025《食品微生物学检验 副溶血性弧菌检验》
- 适用范围: 虽然名为“食品检验”,但其原理和方法是检测副溶血性弧菌(Vibrio parahaemolyticus,水产养殖中最主要的致病弧菌之一)的“金标准”,许多水产检测机构都会参照此方法进行。
- 详细规定了从样品处理、增菌、分离、生化鉴定到血清学鉴定的完整流程,它是一个“全流程”的标准,确保了检测的严谨性和准确性。
- 特点: 方法经典、结果可靠,但操作复杂、耗时长(通常需要3-5天),不适合现场快速筛查。
2 行业标准(SC/HJ):更具针对性,操作性强
行业标准是国家标准的补充和细化,更贴合特定行业的实际需求。
-
核心标准: SC/T 7201.4-2006《水产品中副溶血性弧菌的PCR检测方法》
- 适用范围: 专门针对水产品中副溶血性弧菌的分子生物学检测。
- 利用PCR技术,特异性地扩增副溶血性弧菌的特定基因(如tlh、tdh、trh等),实现快速、灵敏的检测。
- 特点: 速度快(几小时内可出结果)、灵敏度高(能检测到极低数量的细菌),但对实验室设备和人员操作要求较高,是目前大型企业和检测机构的主流方法之一。
-
其他相关标准: 还有一些针对水产养殖环境(如水体、底泥)中总弧菌或特定弧菌的检测方法,可能以农业行业标准(NY)或水产行业标准(SC)的形式发布,具体需查阅最新标准目录。
3 快速检测方法:现场筛查,即时决策
对于广大养殖户而言,快速、便捷、低成本的检测方法更具吸引力。
-
免疫层析试纸条(胶体金法):
- 原理: 类似早孕试纸,利用抗原抗体特异性结合的原理,通过显色条带判断样本中是否含有目标弧菌。
- 优点: 操作极其简单(无需专业培训)、速度快(15分钟出结果)、成本低、适合现场使用。
- 缺点: 灵敏度相对较低,通常为定性或半定量检测,无法区分活菌与死菌,且可能存在交叉反应。
- 应用场景: 日常巡塘时,对养殖水体、虾体表进行初步筛查,快速判断是否存在弧菌污染风险。
-
ATP生物荧光检测法:
- 原理: 检测样本中所有微生物(包括弧菌)的ATP(三磷酸腺苷)含量,ATP含量越高,说明微生物总数越多。
- 优点: 速度极快(1分钟内)、操作简便。
- 缺点: 检测的是总菌数,而非弧菌特异性,只能作为评估水体洁净度和微生物总体状况的辅助工具,不能直接判断弧菌是否超标。
实战操作:如何进行一次标准的弧菌检测?
无论您选择哪种标准,规范的采样和操作流程都是保证结果准确的前提。
第一步:明确检测目标
- 检测什么? 是总弧菌,还是特定的致病弧菌(如副溶血性弧菌、溶藻弧菌)?
- 检测哪里? 是养殖水体、底泥,还是虾、蟹、鱼等养殖动物的体表、鳃、肝胰腺?
- 何时检测? 建议在养殖关键期(如苗种投放前、高温期、病害高发期)定期进行。
第二步:科学采样
- 代表性: 采样点应覆盖池塘的不同区域(进水口、中央、排污口)和不同深度。
- 无菌操作: 使用无菌容器,避免交叉污染,样品应尽快送检或妥善保存(2-8℃冷藏)。
第三步:选择检测方法并送样
- 常规监控: 可使用快速试纸条进行现场初筛。
- 精准诊断/风险评估: 建议将样本送往具备CMA(中国计量认证)资质的专业检测机构,并明确告知对方您希望依据的标准(如GB 4789.7或SC/T 7201.4)。
第四步:解读检测报告 一份合格的报告应包含以下信息:
- 样品信息: 编号、名称、来源等。
- 检测项目: 明确是“总弧菌数 (CFU/mL)”还是“副溶血性弧菌定性/定量”。
- 检测结果: 具体的数值或“检出/未检出”。
- 参考标准/限值: 这是判断风险的关键!参考《无公害食品 海水养殖用水水质》(NY 5052),或企业内部设定的警戒值(如总弧菌 > 10³ CFU/mL 为警戒)。
- 结论与建议: 专业机构会根据结果给出初步的风险评估和防控建议。
防大于治:基于检测结果的弧菌综合防控策略
检测不是目的,防控才是,根据检测结果,我们可以采取以下“组合拳”:
-
生物防控:
- 定期补充有益菌: 如芽孢杆菌、光合细菌、EM菌等,通过竞争排斥和改善水质,抑制弧菌繁殖。
- 培养健康底质: 定期使用底改产品,氧化底层有机物,减少弧菌的“温床”。
-
物理防控:
- 水体消毒: 在弧菌超标或病害爆发前,可谨慎使用过硫酸氢钾、二氧化氯等消毒剂进行水体消毒。注意: 消毒后需及时补充有益菌,避免破坏水体微生态平衡。
- 物理过滤: 使用微滤、砂滤等设备,减少水体中的悬浮物和细菌。
-
化学防控(谨慎使用):
- 在兽医指导下,针对特定病害,可使用国标允许的抗菌药物。严禁滥用抗生素!
-
管理防控:
- 优化投喂: 避免过量投喂,减少残饵污染。
- 加强增氧: 保持水体高溶氧,抑制厌氧弧菌生长。
- 生物安保: 严格管控进水、工具消毒、人员流动,防止外来病原引入。
在水产养殖迈向精细化、智能化的今天,“水产养殖弧菌测试标准” 已不再是遥不可及的专业术语,而是每一位从业者都应掌握的核心技能,它将我们的经验判断,升级为数据驱动的科学决策。
从今天起,请将弧菌检测纳入您的日常管理流程,选择适合您的标准和方法,用科学的数据武装自己,让“隐形杀手”无所遁形,我们才能真正守护好每一片“蓝色粮仓”,实现水产养殖的健康、可持续发展。
【专家寄语】 “养殖先养水,防病先防菌,标准的检测是您养殖事业中的‘火眼金睛’,它能帮您洞察风险,决胜千里,希望本文能成为您案头实用的工具书,祝您养殖顺利,年年丰收!”







